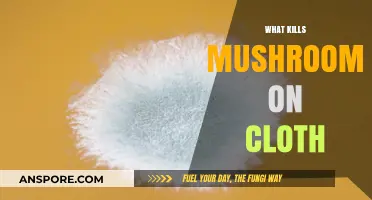
How to Remove Mushrooms from Clothes

Magic mushrooms, also known as shrooms, are naturally occurring psychedelic drugs that can induce hallucinations and distort a person's perception of reality. While some people seek out these effects for recreational or spiritual purposes, others may find themselves experiencing an unpleasant bad trip. In such cases, the question arises: what kills a mushroom high? Various methods and substances, known as trip killers, have been suggested on social media platforms like Reddit, including Xanax, quetiapine, trazodone, and diazepam. However, using these trip killers can be dangerous, and there is a lack of clinical research on their effectiveness. So, what are the safer alternatives to end a bad mushroom trip?
| Characteristics | Values |
|---|---|
| Time to onset | 30-45 minutes |
| Duration | 3-6 hours |
| Early effects | Nausea, yawning |
| Trip effects | Mild: drowsiness, relaxation |
| High doses: hallucinations, anxiety, paranoia, nervousness, distorted sense of time, place, and reality | |
| Very high doses: psychosis | |
| Physical effects | Energy running through the body |
| Mental effects | Thought patterns change, thought loops |
| After-effects | "Afterglow", sleepy feeling |
| Treatment for bad trips | Talk to someone you trust, lie down and listen to soothing music, drink water, drink something sugary |
| Trip killers | Xanax, quetiapine, trazodone, diazepam |
Explore related products
What You'll Learn

Drink water
Drinking water is a good way to help remove the drugs from your system. It can also help relieve any dehydration brought on by alcohol and possibly the nausea from the mushrooms. The act of drinking water is beneficial, but it can also work as a welcome distraction. Focus on the sensation of the water in your mouth and as you swallow it. This will help you get out of your head and into your body, which is a great way to calm down.
It is important to stay hydrated, but drinking water will not significantly reduce the duration of your high. The effects of shrooms can usually be felt around 30 minutes after ingesting them, but it depends on how you consume them. Fresh or dried mushrooms can be ingested on their own, mixed with food, or steeped in hot water or tea. In tea, shrooms can kick in as fast as 5 to 10 minutes after ingestion.
If you are having a bad trip, it is important to stay calm and exercise patience. The most intense effects will pass naturally. Stress and panic will amplify the worst effects, making them seem much worse than they are. If you have someone you can trust, talking to them can be a big help. However, make sure that the person you talk to will not judge you, as even slight judgement can be hurtful when high.
If you are looking to sober up faster, consider drinking something sugary. This will help speed up the rate at which your body metabolises psilocin. Stay away from caffeine, as it will increase feelings of racing thoughts, panic, and anxiety.
Puffballs: Nature's Unique and Edible Mushrooms
You may want to see also

Drink something sugary
Drinking something sugary is one way to reduce the effects of a magic mushroom high. While the high will eventually wear off on its own, this can be a way to speed up the process.
Magic mushrooms, also known as shrooms, contain psilocybin or psilocin, which are hallucinogenic drugs. The effects of a mushroom trip can vary depending on the user's mood, personality, and expectations, and the strength and amount of mushrooms consumed. A trip can be mild, leaving a person feeling drowsy or relaxed, or it can be intense and overwhelming, causing hallucinations, anxiety, paranoia, nervousness, and a distorted sense of time, place, and reality.
If you find yourself in the latter situation and want to reduce the intensity of the high, drinking something sugary can help. Sugar can speed up the rate at which your body metabolises psilocin, helping you to sober up faster. This is a safer option than "trip killers," which are drugs used to end a bad trip, such as Xanax, quetiapine, trazodone, and diazepam. These drugs can be dangerous and have potentially harmful side effects, especially if taken in high doses.
In addition to drinking something sugary, staying hydrated by drinking water can also be beneficial. It can be a welcome distraction, helping you to focus on the sensation of the water in your mouth and going down your throat, bringing you out of your head and into your body, which can be calming.
It's important to note that the effects of magic mushrooms usually last for about 3 to 6 hours, and the high will eventually wear off on its own. If you are feeling overwhelmed, lying down somewhere comfortable, listening to soothing music, and allowing the experience to wash over you may be the best course of action.
Mushroom Brain Boost: Enhancing Cognitive Performance Naturally
You may want to see also

Talk to someone you trust
If you're experiencing a bad mushroom trip, it can be helpful to talk to someone you trust and feel open with. This person should be non-judgmental, as even a hint of judgement can be hurtful when you're high. If you don't have someone you can confide in, it might be best to lie down somewhere comfortable, put on soothing music, and let the experience wash over you. Surrendering to the experience may transform an overwhelming trip into a positive one.
If you're looking to sober up, it's likely because you're having a bad trip. The effects of mushrooms usually last between 3 and 6 hours, and most trips remain within the realm of reality, even if it's distorted. The bulk of the trip lasts between 3 and 4 hours, followed by a 2-hour comedown, so it won't be long before you start to feel sober. However, if you're feeling overwhelmed, there are steps you can take to reduce the intensity of the high.
Drinking water can be a helpful distraction, as you can focus on the sensation of the water in your mouth and throat, bringing you into your body and calming you down. Drinking something sugary can also help speed up the rate at which your body metabolises psilocin. Stay away from caffeine, as it can increase feelings of racing thoughts, panic, and anxiety. If you've already consumed caffeine, try eating a banana to counteract its effects.
While it may seem counterintuitive, sometimes the best course of action is to surrender to the experience. Lying down in a comfortable place and putting on soothing music can help you ride out the high. Remember, the effects of mushrooms are temporary, and the intensity will pass.
If you're looking to sober up because you're concerned about a friend, it's important to provide a calm and non-judgmental environment. Avoid using ""trip killers," as these can be dangerous and have unpredictable effects. Instead, encourage your friend to drink water and offer a sugary drink or a banana if they've consumed caffeine. Most importantly, be present and supportive, and remember that the intensity of the high will pass.
The Ultimate Guide to Braising Mushrooms
You may want to see also
Explore related products

Take a trip killer (Xanax, quetiapine, trazodone, or diazepam)
A "trip killer", also known as a "hallucinogen antidote" or "hallucinogen antagonist", is a drug that can be used to reduce or completely block the effects of a hallucinogenic drug experience or "trip". While trip killers can be used to manage the effects of a "bad trip", they are not without risks and side effects. The use of trip killers is an emerging concern, according to doctors, who warn that information on their use is not readily available through drug advice services.
Xanax
Xanax is a benzodiazepine, a class of drugs that act as sedatives. Benzodiazepines are one of the most frequently recommended types of trip killers, according to an analysis of relevant threads on Reddit. However, they can be addictive and have been implicated in overdose deaths. They can also lead to over-sedation, low blood pressure, and respiratory depression.
Quetiapine
Quetiapine is an antipsychotic drug and another of the most commonly encountered trip killers. It is a serotonin receptor antagonist, which can block or reduce the effects of serotonergic psychedelics. While quetiapine can be effective in managing the effects of a bad trip, the doses recommended on Reddit (25-600 mg) are high and may be non-optimal or excessive, increasing the risk of side effects.
Trazodone
Trazodone is an antidepressant that acts as a serotonin antagonist and reuptake inhibitor. It is commonly used as a trip killer, especially in cases where the trip needs to be stopped immediately, such as during a panic attack. It is not a controlled substance and is readily available by prescription.
Diazepam
Diazepam is another benzodiazepine that is sometimes used to manage the effects of serotonergic psychedelics, including in clinical settings. Like other benzodiazepines, it can be useful in managing dissociative intoxication, but it can also increase sedation and associated risks.
Joe's Special: Mushroom Mystery Solved
You may want to see also

Avoid caffeine
While there is no sure-fire way to "kill" a mushroom high, there are some strategies that may help reduce the intensity of the high or bring you down from the high more quickly. One important thing to keep in mind is to avoid caffeine.
Caffeine should be avoided when trying to reduce the effects of a mushroom high because it can increase feelings of anxiety and panic. These negative feelings are already common side effects of a bad trip, and caffeine will only serve to exacerbate them. If you have already consumed caffeine, eating a banana may help to counteract its effects to some extent.
In general, it is important to be cautious when taking any type of drug, including magic mushrooms. Mushrooms can affect everyone differently, and the experience can depend on various factors such as the user's mood, personality, expectations, and physical and mental health history. It is also crucial to distinguish between magic mushrooms and poisonous mushrooms, as the latter can be extremely harmful and even fatal.
If you are looking for ways to reduce the intensity of a mushroom high or come down from it more quickly, there are a few other strategies that may help. Firstly, it is important to stay hydrated by drinking water. This can be a helpful distraction, allowing you to focus on the sensation of the water in your mouth and going down your throat, bringing you out of your head and into your body. Additionally, drinking something sugary can help speed up the rate at which your body metabolizes psilocin, aiding in sobering up faster.
Another strategy is to talk to someone you trust and feel comfortable with. Having a supportive person to talk to can be immensely helpful, as long as they are non-judgmental. If talking is not an option, lying down somewhere comfortable, listening to soothing music, and allowing yourself to experience the high without judgment can also be beneficial.
It is important to note that there is limited clinical research on "trip killers" or ways to end a bad trip. Some sources suggest using anxiolytics like benzodiazepines (e.g., Xanax or Valium) to decrease the anxiety associated with the trip, but these drugs come with their own risks and can be highly addictive. As such, it is generally best to avoid attempting to "kill" a mushroom high with other substances unless under medical supervision.
How Mushrooms Grow: No Seeds Required
You may want to see also
Frequently asked questions
A mushroom high, also known as a "trip", is caused by the hallucinogenic effects of psilocybin or psilocin, the active compounds in "magic mushrooms". The effects can range from mild to intense and can include visual, auditory, and physical sensations, as well as changes in thought patterns and emotions.
Mushroom highs can have risks, including unpleasant physical effects, delayed headaches, and negative mental health effects. Mixing mushrooms with other drugs or consuming them while experiencing mental health issues can increase these risks. Additionally, there is a risk of consuming poisonous mushrooms, which can lead to severe illness or even death.
The effects of a mushroom high typically last between 3 to 6 hours, with the intensity dwindling in the two hours following the peak. Most people then experience an "afterglow", a comfortable and sleepy feeling that is not quite sober but no longer high.
If you are experiencing a bad mushroom trip, it is recommended to seek support from a trusted individual who will not judge you. Drinking water can also be helpful, as it provides a distraction and has a calming effect. Consuming something sugary may help speed up the metabolism of psilocin and sober you up faster. However, it is important to avoid caffeine, as it can increase feelings of anxiety and racing thoughts.

![KILLER HIGH [DVD]](https://m.media-amazon.com/images/I/610Mna2i8rL._AC_UY218_.jpg)